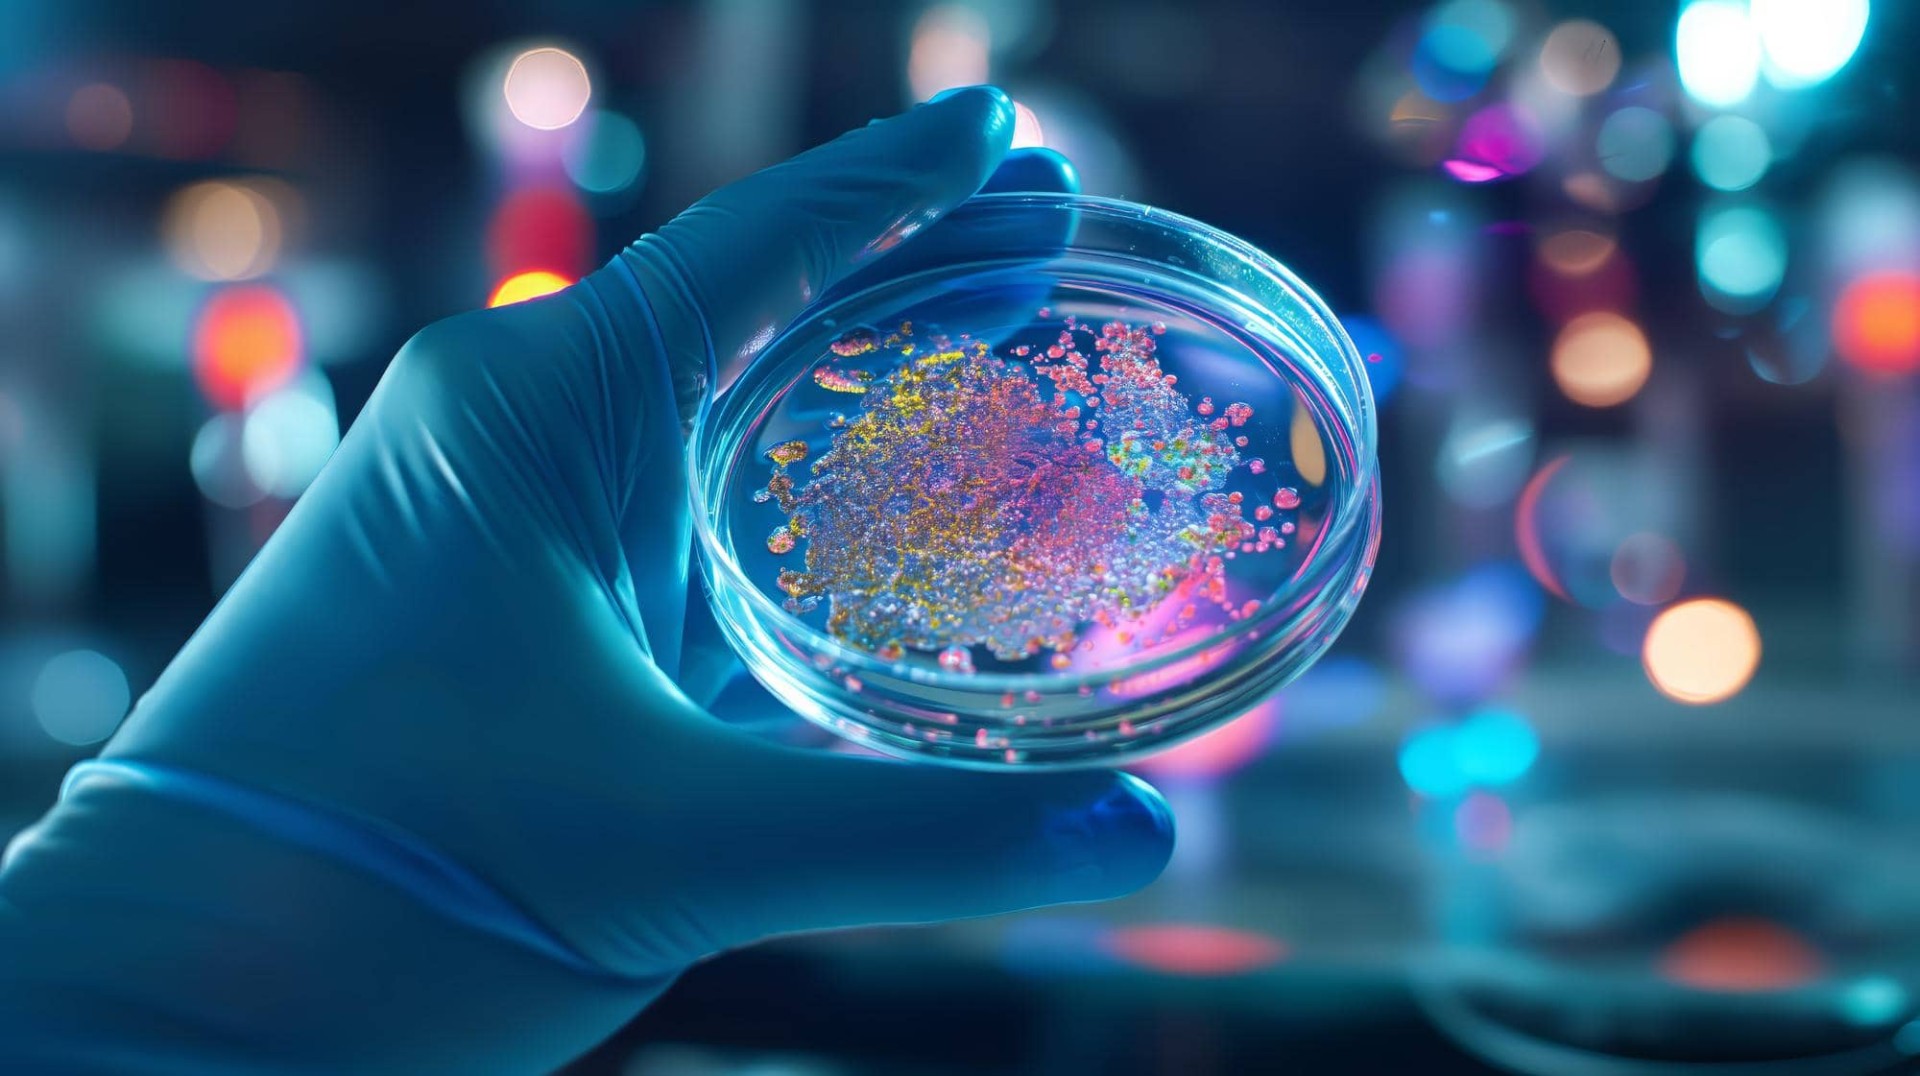
peptides & related nanostructures

The COST Action SNOOPY brings together a network of experts and young researchers from diverse disciplines - chemistry, biology, biochemistry, materials science, nanotechnology, medicine, physics - to overcome existing barriers to predict and implement bioactive peptides’ ability to self-assemble into functional nanostructures.
Why It Matters
Peptide-based nanostructures have strong potential in drug delivery, biomaterials, and disease treatment. SNOOPY promotes interdisciplinary collaboration to help turn scientific discoveries into real-world applications.
Join the Network
SNOOPY brings together experienced researchers and young scientists in an international platform for collaboration, knowledge exchange, and innovative research.
This Action includes 4 Working Groups (WGs) that will be interconnected to ensure effective collaboration among participants.

Development of in silico and ML approaches to assist with the prediction and design of bioactive peptides and peptide nanostructures.

Improve the production, sustainability, and efficiency of bioactive peptides and nanostructures while advancing their study through enhanced characterization techniques.
Advance the biological understanding and applications of bioactive peptides and nanostructures for healthcare and technology.

Working Group 4 will ensure continuous and effective dissemination within and beyond the Action throughout its duration.
Whether you're an experienced researcher or an early-career scientist eager to contribute, the COST Action SNOOPY provides a collaborative, international platform for knowledge exchange, cutting-edge research, and interdisciplinary collaboration.
We use cookies to improve your experience. Agreeing allows us to analyze browsing behavior. Opting out may affect features.